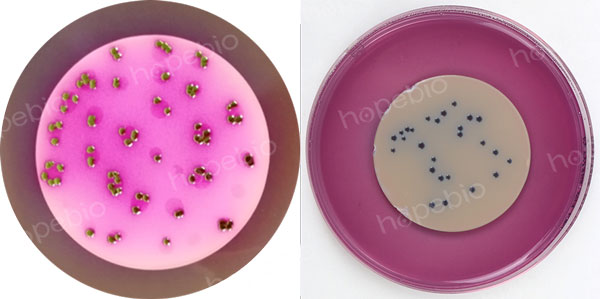

海博微信公众号
海博微信公众号
 海博天猫旗舰店
海博天猫旗舰店


 海博微信公众号
海博微信公众号
 海博天猫旗舰店
海博天猫旗舰店




引言
微生物监测是评估近岸河流水环境质量的重要环节,为确保微生物样品的代表性、完整性和检测数据的准确性,规范微生物样品的保存、运输及交接流程,参考《水和废水监测分析方法(第四版)》,对微生物样品的保存、运输及交接流程进行系统阐述,以期为实际监测工作提供参考。
对于样品采集及采样点位设置的相关内容可参考《近岸河流水域微生物取样方法及注意事项》及《近岸河流水域微生物采样点位的布置方法及注意事项》。
一、水样的保存
1.导致水质变化的因素
水样采集后,应尽快送到实验室分析。样品久放,受下列因素影响,某些组分的浓度可能会发生变化。
① 生物因素:微生物的代谢活动和其它生物的作用会影响测定样品的指标浓度,且影响多种被测成分的化学性质,如pH、溶解氧、生化需氧量、氧化碳、碱度、硬度、磷酸盐、硫酸盐、硝酸盐和某些有机化合物的浓度变化上。
② 化学因素:测定组分可能被氧化或还原,某些沉淀与溶解、聚合物产生或解聚作用的发生。均能导致测定结果与水样实际情况不符。
③ 物理因素:测定组分被吸附在容器壁上或悬浮颗粒物的表面上,如溶解的金属或胶状的金属,某些有机化合物以及某些易挥发组分的挥发损失。
2.水样保存方法
① 冷藏或冷冻:样品在4℃冷藏或将水样迅速冷冻,贮存于暗处,可以抑制生2物活动,减缓物理挥发作用和化学反应速度。但需要注意冷藏保存不能超过规定的保存期限,冷藏温度必须控制在4℃左右。温度太低,因结冰体积膨胀,使容器破裂,或样品瓶盖被顶开失去密封,样品受沾污。
② 加入化学保存剂:对于非微生物检测相关的其他水样检测项目,如总铬、酚、硝酸盐、亚硝酸盐、汞等成分。可通过以下方法:控制溶液pH值、加入抑制剂、加入氧化剂等。
对于微生物检测相关的水样检测项目,可加入还原剂:
含余氯水样,能氧化氰离子,可使酚类、烃类、苯系物氯化生成相应的衍生物,为此在采样时加入适量的硫代硫酸钠予以还原,除去余氯干扰。
3.水样的保存条件
① 保存条件
不同监测项目样品的保存条件不同。由于地表水、废水(或污水)样品的成分不同,同样保存条件很难保证对不同类型样品中待测物都是可行的。因此,在采样前应根据样品的性质、组成和环境条件,要检验保存方法或选用的保存剂的可靠性。对于微生物检测项目,保存条件参考表1。
表1微生物检测项目保存条件
|
项目 |
采样容器 |
保存剂用量 |
保存期 |
采样量 |
容器洗涤 |
|
微生物 |
聚乙烯瓶等 |
加入硫代硫酸钠至0.2-0.5g/L除去余氯,4℃保存 |
12h |
250mL |
I |
② 容器的洗涤方法
I,I,Ⅲ,IV表示四种洗涤方法,如下:
I:洗涤剂洗一次,自来水三次,蒸馏水一次。对于采集微生物和生物的采样容器,须经160℃干热灭菌2 h。经灭菌的微生物和生物采样容器必须在两周内使用,否则应重新灭菌;经121℃高压蒸汽灭菌15 min的采样容器,如不立即使用,应于60℃将瓶内冷凝水烘干,两周内使用。细菌监测项目采样时不能用水样冲洗采样容器,不能采混合水样,应单独采样后2 h内送实验室分析。
Ⅱ:洗涤剂洗一次,自来水洗二次,(1+3)HNO3荡洗一次,自来水洗二次,蒸馏水一次;
Ⅲ:洗涤剂洗一次,自来水洗二次,(1+3)HNO3荡洗一次,自来水洗三次,去离子水一次;
IV:铬酸洗液洗一次,自来水洗三次,蒸馏水洗一次。如果采集污水样品可省去用蒸馏水、去离子水清洗的步骤。
二、水样的管理与运输
1.水样的管理
样品是从各种水体及各类型水中取得的实物证据和资料,水样妥善而严格的管理是获得可靠监测数据的必要手段。
水样采集后,往往根据不同的分析项目,分装成数份,并分别加入保存剂。对每一份样品都应附一张完整的水样标签。水样标签的设计可以根据实际情况,一般包括:采样目的,监测点数目,位置,监测日期,时间,采样人员等。标签使用不褪色的墨水填写,并牢固地贴于盛装水样的容器外壁上。
2.水样的运输和交接
水样采集后必须立即送回实验室,根据采样点的地理位置和每个项目分析前最长可保存的时间,选用适当的运输方式,在现场工作开始之前,就要安排好水样的运输工作,以防延误。
每个水样瓶均需贴上标签,内容有采样点位编号、采样日期和时间、测定项目、保存方法,并写明用何种保存剂。对于大量样品的运输或对项目有明确要求的,在样品运输过程中应有押运人员,防止样品损坏或受污。移交实验室时,应核对样品,办妥交接手续。
污水样品的组成往往相当复杂,其稳定性通常比地表水样更差,应设法尽快测定。
三、水样的延迟检测
延迟培养法可以允许水样经滤膜过滤后,将滤膜装运、输送到实验室,进行培养并完成检验。
在测定水中总大肠菌群、粪大肠菌群时,若在常规的检验步骤不能实现时,例如运输的途中不能保证所要求的温度,或在采样后不能在允许的时间内进行检验等都可应用延迟培养。
延迟培养试验基本上是依照检验总大肠菌群和粪大肠菌群的滤膜法进行修正而来的。此法是将水样在现场过滤后,将滤膜置于培养基上,然后运到实验室。这种运送滤膜的培养基能在运输过程中保持大肠菌群细菌的活性,但又不允许它们在运输到实验室的途中长成可见的菌落。
其操作步骤为:在采集水样后,立即进行过滤,将滤膜安放在运输培养基(LES-MF保存性培养基、)上,再送到实验室;在实验室将滤膜转移到检测培养基上(总大肠菌群为LES-Endo琼脂培养基,粪大肠菌群为MFC培养基),进行培养及后续检测。下图为大肠菌群及粪大肠菌群分别在两种培养基上的生长特征(图1)。
|
|
|
LES-Endo琼脂培养基 |
MFC琼脂培养基 |
图1 大肠菌群及粪大肠菌群在LES-Endo琼脂及MFC琼脂上的菌落特征
四、运输及检测培养基的采购
开云手机登录中心有延迟培养试验所使用运输培养基及检测培养基,客户可根据实际情况和用途进行选用。
|
产品编号 |
产品名称 |
规格 |
产品说明及用途 |
|
HB8776 |
100g |
用于水样的保存和运输 |
|
|
HB0161 |
250g |
用于水中大肠菌群滤膜法计数 |
|
|
HB0154 |
250g |
用于生活饮用水及其水源水中粪大肠菌群测定 (GB标准) |
|
|
HBPM020 |
10个/包 |
用于粪大肠菌群的滤膜法检测 |
注:本文属海博生物原创,未经允许不得转载。
上一篇:如何正确选择植物外植体
下一篇:没有了!
| 相关文章: | |



